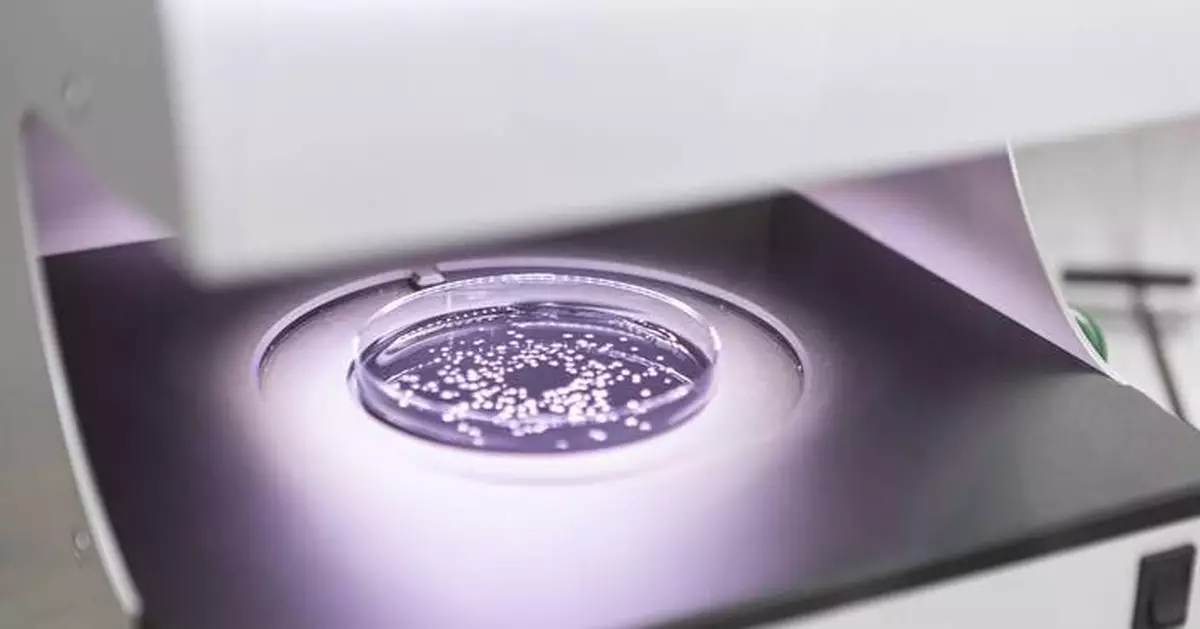
A natural breakthrough in protecting cereals and field crops

BASEL, Switzerland & CHASSIEU, France--(BUSINESS WIRE)--Nov 18, 2025--
Amoebas. These single-celled microorganisms are now at the heart of one of agriculture’s latest biological innovation – a bio-fungicide capable of protecting wheat and other cereal crops from crippling fungal diseases that cost global agriculture billions of dollars in annual crop losses and quality.
This press release features multimedia. View the full release here: https://www.businesswire.com/news/home/20251117217798/en/
This new development, made from the lysate of the amoeba Willaertia magna C2c Maky, holds strong potential to advance biological crop protection. In trials, the candidate demonstrated its effectiveness in combating the fungi responsible for these fungal diseases and helped activate the plants' defence responses. As a next‑generation biological, it is built on a biological active substance and designed to fit modern integrated crop management.
Syngenta Crop Protection, a global leader in biologicals and other innovative crop protection technologies, and French greentech innovator Amoéba SA, have now signed a Memorandum of Understanding to develop and commercialize groundbreaking biocontrol solutions for the EU and UK markets, focusing on cereals and field crops. The parties plan to negotiate a definitive distribution agreement with a target timeline of spring 2026. This strategic collaboration aims to offer farmers advanced biological solutions that enhance the sustainability of their farming practices, address the challenge of increasing pest resistance to existing products, and offer relief to farmers facing a shrinking toolbox of crop protection technologies.
The initial focus of the partnership will be on combating the main wheat diseases, namely septoria tritici blotch (STB) and yellow rust. These two diseases are among the most economically damaging wheat diseases across Europe and the UK, impacting an estimated 9-12 million hectares of wheat annually. In Germany alone, STB causes yield losses of 5-50% and costs of €1.5 billion annually, while yellow rust can reduce yields by 10-70% and even lead to total crop failure in susceptible varieties, according to recognized industry and academic sources.
Matthew Pickard, Syngenta’s Head of Seedcare and Biologicals for Europe, said: “At Syngenta, we are committed to deliver advanced, effective biological solutions at the cutting edge of science. We’re proud to work with Amoéba to offer nature-inspired solutions that empower farmers in these important markets.”
“We are very pleased with the collaboration with Syngenta, a global leader in agricultural innovation,” affirms Benoit Villers,Chairman of the Board of Amoéba and Jean-François Doucet, CEO of Amoéba. "This agreement, which should lead to distribution and development partnerships between our two companies, is a major step forward for Amoéba. It gives us the opportunity to combine our scientific expertise with Syngenta's widely recognised leadership in cereal protection and the marketing of biocontrol solutions. Finally, it perfectly illustrates how collaboration between innovators in the sector can make a difference for farmers while paving the way for broader applications in field crops."
Founded in 2010, Amoéba has developed a patented biocontrol application based on lysate from the amoeba Willaertia magna, which received the prestigious Bernard Blum Gold Medal in October 2025 as the most promising biocontrol solution worldwide. In June 2025, the active substance received EU approval following EFSA’s scientific assessment and a European Commission decision. Product‑specific authorizations are in progress.
About Syngenta
Syngenta is a global leader in agricultural innovation with a presence in more than 90 countries. Syngenta is focused on developing technologies and farming practices that empower farmers, so they can make the transformation required to feed the world’s population while preserving our planet. Its bold scientific discoveries deliver better benefits for farmers and society on a bigger scale than ever before. Guided by its Sustainability Priorities, Syngenta is developing new technologies and solutions that support farmers to grow healthier plants in healthier soil with a higher yield. Syngenta Crop Protection is headquartered in Basel, Switzerland; Syngenta Seeds is headquartered in the United States. Read our stories and follow us on LinkedIn, Instagram & X.
About Amoéba
Founded in 2010, Amoéba is a greentech company based in Chassieu (Lyon, France) whose ambition is to become a major player in the treatment of microbiological risk based on the patented use of amoebae in the plant protection and cosmetics sectors.
With know-how that is unique in the world and protected by numerous patents, Amoéba is currently the only company capable of exploiting the full potential of the Willaertia amoeba on an industrial scale and cultivating it in sufficient volumes to offer biological solutions that constitute a viable alternative to the chemical products widely used today. Amoéba is currently focusing on the global biocontrol market for plant protection and on the cosmetics market. As the marketing of plant protection products is subject to obtaining local regulatory authorisations, the Company has carried out the necessary regulatory procedures and filed registration dossiers in Europe and the United States. The active substance has obtained approval in 2022 in the USA and in 2025 in Europe. Product approvals have been granted in the USA and are expected in the coming months in Europe.
The cosmetic application does not require prior approval from a competent authority in Europe or the United States. The cosmetic ingredient is already registered on the INCI (International Nomenclature of Cosmetic Ingredients) list, paving the way for it to be marketed worldwide except in China, where local approval is required.
Amoéba is listed on Euronext Growth (ALMIB). The company is a member of the Bpifrance Excellence network and is eligible for the PEA-PME scheme.
For more information, visit www.amoeba-nature.com
Data protection is important to us. You are receiving this publication on the legal basis of Article 6 para 1 lit. f GDPR (“legitimate interest”). However, if you do not wish to receive further information about Syngenta, just send us a brief informal message and we will no longer process your details for this purpose. You can also find further details in our privacy statement.
Syngenta’s Cautionary Statement Regarding Forward-Looking Statements
This document may contain forward-looking statements, which can be identified by terminology such as ‘expect’, ‘would’, ‘will’, ‘potential’, ‘plans’, ‘prospects’, ‘estimated’, ‘aiming’, ‘on track’ and similar expressions. Such statements may be subject to risks and uncertainties that could cause the actual results to differ materially from these statements. For Syngenta, such risks and uncertainties include risks relating to legal proceedings, regulatory approvals, new product development, increasing competition, customer credit risk, general economic and market conditions, compliance and remediation, intellectual property rights, implementation of organizational changes, impairment of intangible assets, consumer perceptions of genetically modified crops and organisms or crop protection chemicals, climatic variations, fluctuations in exchange rates and/or commodity prices, single source supply arrangements, political uncertainty, natural disasters, and breaches of data security or other disruptions of information technology. Syngenta assumes no obligation to update forward-looking statements to reflect actual results, changed assumptions or other factors.
©2025 Syngenta. Rosentalstrasse 67, 4058 Basel, Switzerland.

Syngenta and Amoeba SA to develop and commercialize biocontrol solutions for EU and UK